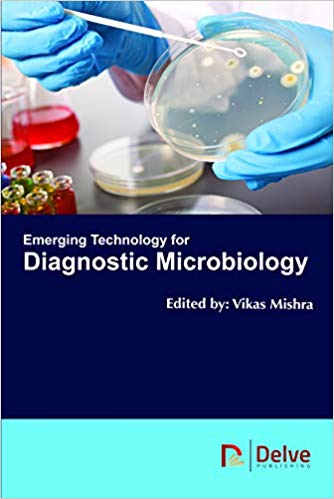
(eBook PDF)Emerging Technology for Diagnostic Microbiology by Vikas Mishra

Shop
Filters
Showing 5581–5589 of 18045 results
Filter by price
Products
Save up to 80% by choosing the PDF eBook vs printed books
High-quality searchable PDF format, ideal for printing
No expiration date! No DRM protection. Access your PDF ebook anytime and anywhere.